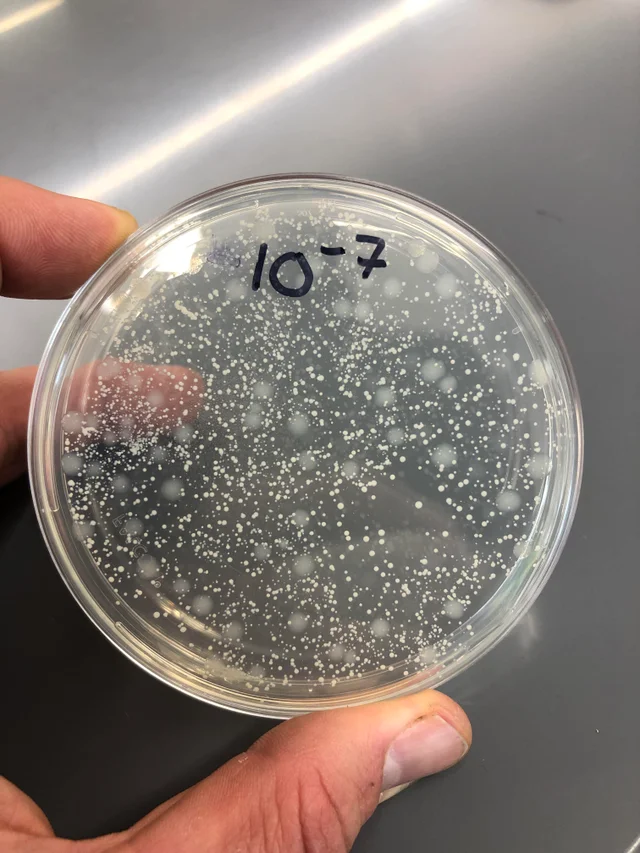

Reasons Why You Should Not Drink Tap Water
1. Escherichia coli - E.coli in the tap water
Image source/ Reddit
We've all heard of E.coli, right? It's a bacteria that causes vomiting and sickness, stomach cramps and pains as well as diarrhea. When the water supply has been contaminated with human or animal waste, E.coli might be found in small traces in our tap water!Advertisement
2. You might be consuming arsenic!

Image source/ Reddit
Arsenic is a naturally occurring metalloid chemical that comes from underground. If you consume too much, it can cause arsenic poising which can lead to you becoming very ill and it can also cause damage to your body. Arsenic may be present in industrial places, but not usually in household water supplies.Advertisement
3. Chlorine - the same chemical used in pools

Image source/ Reddit
Chlorine is used in water to kill germs and keep them clean, for example, when swimming. But it may also be present in tap water too. However, the consumption of chlorine is not good. And if you intake too much chlorine it can damage the body if you consume too much as well as make you sick.Advertisement
4. Diethyl Phthalate is found in plastics and could be in your water!

Image source/ Reddit
Diethyl Phthalate - this is a substance which can be found in many flexible plastics. Due to the fact that there are now so many flexible plastics littered around and in landfill, it may absorb into the water supply and contaminate your tap water. This chemical may affect sex hormones and sperm count.Advertisement
5. Too much fluoride can damage your bones

Image source/ Reddit
Fluoride is naturally found mineral found in water, bones, teeth, and plants. But in excess is not good and can be very damaging for your bones. Fluoride may be found in tap water in different levels, depending where the water source is coming from and how it has been treated.Advertisement
6. You could be drinking heavy metals

Image source/ Reddit
Heavy metals are things such as, copper, lead, mercury, aluminium etc and they may be found in tap water. And these metals in too much quantity can be toxic for our bodies and it can lead to different kinds of health problems. For example, aluminium overload has been linked to Alzheimer's.Advertisement
7. Pesticides and herbicides which kill insects may be found in our water

Image source/ Reddit
Pesticides and herbicides are the chemicals which are used to kill insects and they can, through the ground, be absorbed and end up in the water supply. If we consume too much of these strong chemicals it may cause symptoms such as weakness, headaches, and irritation of the skin and eyesAdvertisement
8. Water softening might not be all good...

Image source/ Reddit
Water softening is the process of removing harmful substances from the water so that it's safe to drink. It involves the ions being replaced by sodium chloride. But too much sodium chloride could lead to stomach issues and vomiting amongst other symptoms.Advertisement
9. It could contain nitrates found in bacon

Image source/ Reddit
Nitrates can occur naturally in water and air as well as things such as processed ham, hot dog sausage and bacon. And it may be in tap water too! But it could, in extreme cases lead to methemoglobinemia which can lead to not enough water supply in the body's cells.Advertisement
10. Radon - a dangerous gas which could be in the tap water

Image source/ Reddit
Radon gas that is found in the air. It is created when water runs through rocks containing uranium, and it then causes a process which releases radon into the water. Radon is not safe to consume, but through this process it could be in tap water. Radon consumed over time could even cause cancers of the internal organs.Advertisement
11. It could contain Legionella, an infection causing bacteria

Image source/ Reddit
Legionella is a kind of bacteria. And, while it's not likely to be in our tap water, if the water has been contaminated in some way (which could happen!) this is one of the bacteria likely to be found. When you consume a lot of this bacteria it can affect the lungs and could also cause infections.Advertisement
12. Salmonella, which causes food poisoning

Image source/ Reddit
And another kind of bacteria which we all know about...salmonella. It's not pleasant to think that this could be in our drinking tap water . As you probably are aware - salmonella can cause food poisoning and stomach problems, infections of the intestines as well as fevers.Advertisement
13. Phosphates, the substance found in fertilizer could be in the water

Image source/ Reddit
Phosphates are found in detergents and fertilizers, which of course, means that it is a strong chemical not meant for human consumption. If the chemical is absorbed into the ground it's possible it leaks into the water supply and therefore, our tap water. If this chemical is present in larger amounts within your body it could cause a hardening of the arterial walls.Advertisement
14. Pharmaceuticals in the water supply - you could be drinking medication

Image source/ Reddit
If you think about it, pharmaceutical medications such as antibiotics, birth control, pills to stabilize mood could all be found in small traces in our tap water. If they are flushed down the toilet, for example, or present in people's waste which enters into the sewage, it means low levels of them could be found in tap water. It's yet unknown what effect it can have on the human body.Advertisement
15. Dioxins, toxic chemicals

Image source/ Reddit
Dioxins are produced from big chemical factories. They have been linked to causing cancers and reproductive problems in various studies. While dioxins are only produced in certain industries, they could still possibly be found in very small traces within tap water.Advertisement
16. In some places it's not safe to drink at all!

Image source/ Reddit
So we've covered the reasons not to drink tap water in places where it is safe to drink tap water. But, sometimes you cannot drink the water as it is not safe and it can make you sick. For example, in some countries the water is not suitable for consumption and there's no other choice but to drink bottled water.Advertisement
17. The standards vary in each place

Image source/ Reddit
Each place has a different water treatment service, and each water treatment place has different standards or processes. For example, some water supplies contain more of one chemical or a certain mineral than others. So you never truly know what makes u the tap water in different places.Advertisement
18. You can't guarantee taste

Image source/ Reddit
You've probably noticed that wherever you go, the water tastes different. It's true that in the mountains the water seems to taste fresher. And when you go to different town, the water tastes, smells and looks different. So if you want guaranteed taste wherever you are, you can't get this from tap water as it inevitably varies!Advertisement
19. You won't make the bottle water companies extra money

Image source/ Reddit
Now this point is of course not really a negative. Bottled water companies of course, would love us all to drink water from bottles instead of the taps. The pros and cons vary, however, plastic consumption is definitely something that has to be considered.Advertisement
20. Bottled water follows strict regulations

Image source/ Reddit
Bottled water has to follow very strict health and safety regulations and guidelines in order to be sold. This should mean that the water is very safe to drink, and should not contain anything nasty which could make us sick or be damaging to our body or our health.Advertisement
21. Bottled water contains extra minerals

Image source/ Reddit
Another positive of bottled water over tap water is that there are added vitamins and minerals in certain bottled waters. There are also these present in tap water, but there may be more in bottled water. These minerals can be good for our overall health.Advertisement
22. Tap water is harder to carry around

Image source/ Reddit
Okay so if you have a reusable water bottle then this combats this issue, and it's environmentally friendly. BUT, in some places it's hard to find tap water to refill your bottle. Bottled water is always available at a store and so it's super convenient to pick one up and hydrate.Advertisement
23. It could be less filtered

Image source/ Reddit
Tap water in some places may be less filtered than certain bottled water companies. Filtering includes the removal of harmful things, to make it safer to drink. So, with bottled water you could be drinking water which has been through a more thorough filtering system.Advertisement
24. Bottled water can encourage you to hydrate

Image source/ Reddit
There's something about carrying a bottle of water around with you which just encourages you to drink it. When you see water, you want to drink. When you don't it's much easier to forget. And drinking water is super important for a healthy body and mind.Advertisement
25. You can't choose the taste that suits you

Image source/ Reddit
With tap water, whatever the water is like in your area, that's the only option you have. But with bottled water, you can find a water that suits your taste. There are more options when it comes to how they taste and then when you find the one you like, that's the bottled water you can buy.Advertisement
26. You have to have clean pipes

Image source/ Reddit
So when the water is coming straight to your glass, it doesn't linger in the pipes long enough to cause any harmful chemicals that may have been in the pipes. But sometimes, with old systems in the bathroom for example, the water may stay in the pipes meaning that it could carry whatever was on the pipe right to your glass.Advertisement
27. Sometimes its not cold...

Image source/ Reddit
It's not exactly a huge complaint that your water is sometimes not ice cold to drink. But, it makes a different, right? Luke warm water versus fridge cold water. It's no contest. And yes, it's hardly a huge reason not to drink tap water, but it's certainly a factor. Unless you have ice cold pipes!Advertisement
28. You can't pick which source it comes from

Image source/ Reddit
On thing you cannot do when you have tap water is choose where it comes from, because it comes from the most locally water source to you. When you choose bottles water you can choose whether it comes from the mountains, or a water springs, or even a well for example.Advertisement
29. Everywhere sells bottled water

Image source/ Reddit
So it couldn't be more easy to just to pick up a bottled water. But tap water? It's not so easy when you're out and about for the day. It's certainly becoming more frequent to find refilling stations. But otherwise apart from a public bathroom it's very difficult to get to a tap to refill your bottle!Advertisement
30. Tap water doesn't create as many jobs

Image source/ Reddit
There is the fact that bottled water creates jobs, for example, millions of people who make the bottles at factories, distribute the bottled water and sell them at the store as well as the plastic waste removal jobs. In tap water, there are the water treatment factories and that is all.Advertisement
